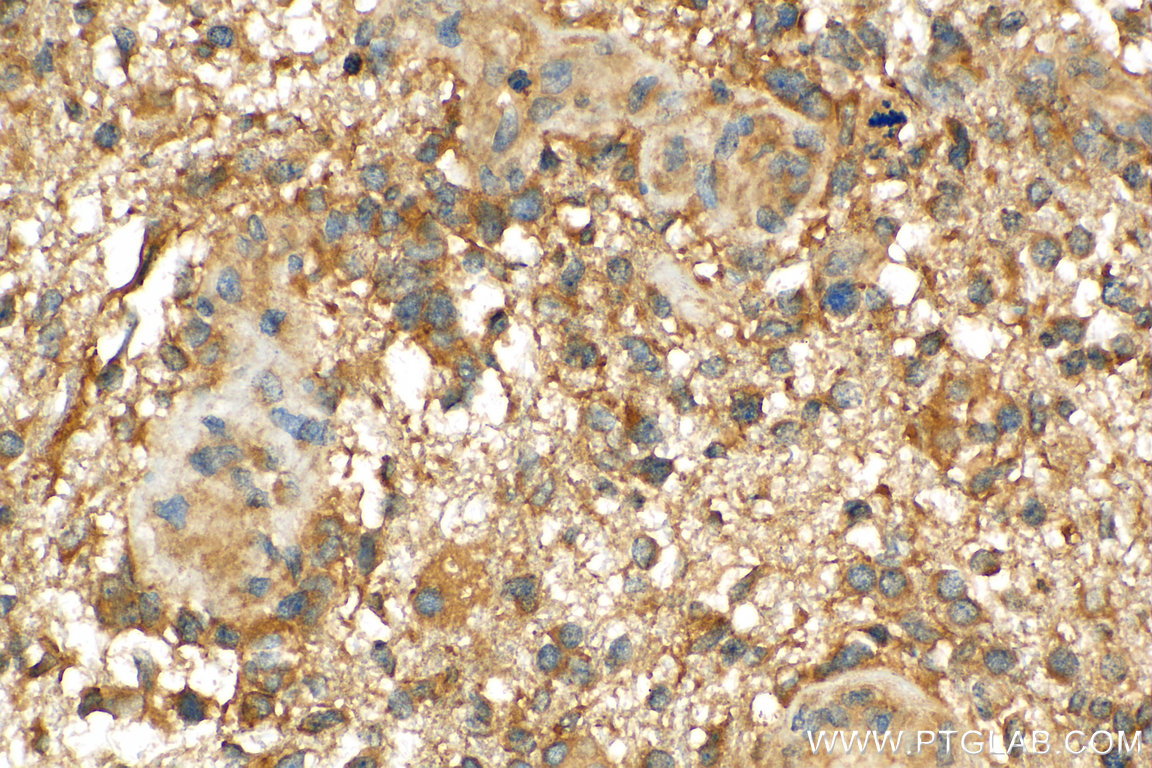

验证数据展示
经过测试的应用
| Positive WB detected in | A549 cells, HeLa cells, mouse kidney tissue, HepG2 cells |
| Positive IP detected in | HeLa cells |
推荐稀释比
| 应用 | 推荐稀释比 |
|---|---|
| Western Blot (WB) | WB : 1:1000-1:5000 |
| Immunoprecipitation (IP) | IP : 0.5-4.0 ug for 1.0-3.0 mg of total protein lysate |
| It is recommended that this reagent should be titrated in each testing system to obtain optimal results. | |
| Sample-dependent, Check data in validation data gallery. | |
产品信息
10181-2-AP targets ATG5 in WB, IHC, IF, IP, CoIP, ELISA applications and shows reactivity with human, mouse, rat samples.
| 经测试应用 | WB, IP, ELISA Application Description |
| 文献引用应用 | WB, IHC, IF, IP, CoIP |
| 经测试反应性 | human, mouse, rat |
| 文献引用反应性 | human, mouse, rat, pig, monkey, chicken, bovine, hamster, goat, grouper |
| 免疫原 |
CatNo: Ag0214 Product name: Recombinant human ATG5 protein Source: e coli.-derived, PGEX-4T Tag: GST Domain: 28-275 aa of BC002699 Sequence: TEREAEPYYLLLPRVSYLTLVTDKVKKHFQKVMRQEDISEIWFEYEGTPLKWHYPIGLLFDLLASSSALPWNITVHFKSFPEKDLLHCPSKDAIEAHFMSCMKEADALKHKSQVINEMQKKDHKQLWMGLQNDRFDQFWAINRKLMEYPAEENGFRYIPFRIYQTTTERPFIQKLFRPVAADGQLHTLGDLLKEVCPSAIDPEDGEKKNQVMIHGIEPMLETPLQWLSEHLSYPDNFLHISIIPQPTD 种属同源性预测 |
| 宿主/亚型 | Rabbit / IgG |
| 抗体类别 | Polyclonal |
| 产品类型 | Antibody |
| 全称 | ATG5 autophagy related 5 homolog (S. cerevisiae) |
| 别名 | APG5, APG5 LIKE, APG5L, APG5-like, Apoptosis specific protein |
| 计算分子量 | 32 kDa |
| 观测分子量 | 32 kDa, 40-45 kDa, 50-55 kDa |
| GenBank蛋白编号 | BC002699 |
| 基因名称 | ATG5 |
| Gene ID (NCBI) | 9474 |
| RRID | AB_2062045 |
| 偶联类型 | Unconjugated |
| 形式 | Liquid |
| 纯化方式 | Antigen affinity purification |
| UNIPROT ID | Q9H1Y0 |
| 储存缓冲液 | PBS with 0.02% sodium azide and 50% glycerol, pH 7.3. |
| 储存条件 | Store at -20°C. Stable for one year after shipment. Aliquoting is unnecessary for -20oC storage. |
背景介绍
ATG5, also named as APG5L and ASP, belongs to the ATG5 family. It is required for autophagy. It plays an important role in the apoptotic process, possibly within the modified cytoskeleton. Its expression is a relatively late event in the apoptotic process, occurring downstream of caspase activity. Autophagy is a catabolic process for the autophagosomic-lysosomal degradation of bulk cytoplasmic contents. Formation of the autophagosome involves a ubiquitin-like conjugation system in which Atg12 is covalently bound to Atg5 and targeted to autophagosome vesicles. It mediates autophagosome-independent host protection. This antibody is raised against 28-275 amino acids of human ATG5. It can recognize the ATG5-ATG12 complex (55 kDa) which can be truncated and generate a 40-45 kDa band. 10181-2-AP also recognizes the free ATG5 (32 kDa).
实验方案
| Product Specific Protocols | |
|---|---|
| IHC protocol for ATG5 antibody 10181-2-AP | Download protocol |
| IP protocol for ATG5 antibody 10181-2-AP | Download protocol |
| WB protocol for ATG5 antibody 10181-2-AP | Download protocol |
| Standard Protocols | |
|---|---|
| Click here to view our Standard Protocols |
发表文章
| Species | Application | Title |
|---|---|---|
Signal Transduct Target Ther Targeting CRL4 suppresses chemoresistant ovarian cancer growth by inducing mitophagy | ||
Cell Res Degradation of lipid droplets by chimeric autophagy-tethering compounds.
| ||
Mol Cell Syntaxin 13, a Genetic Modifier of Mutant CHMP2B in Frontotemporal Dementia, Is Required for Autophagosome Maturation.
| ||
Adv Sci (Weinh) SETDB1 Methylates MCT1 Promoting Tumor Progression by Enhancing the Lactate Shuttle | ||
Autophagy Autophagy mediates the clearance of oligodendroglial SNCA/alpha-synuclein and TPPP/p25A in multiple system atrophy models | ||
J Clin Invest Acetaldehyde dehydrogenase 2 interactions with LDLR and AMPK regulate foam cell formation. |